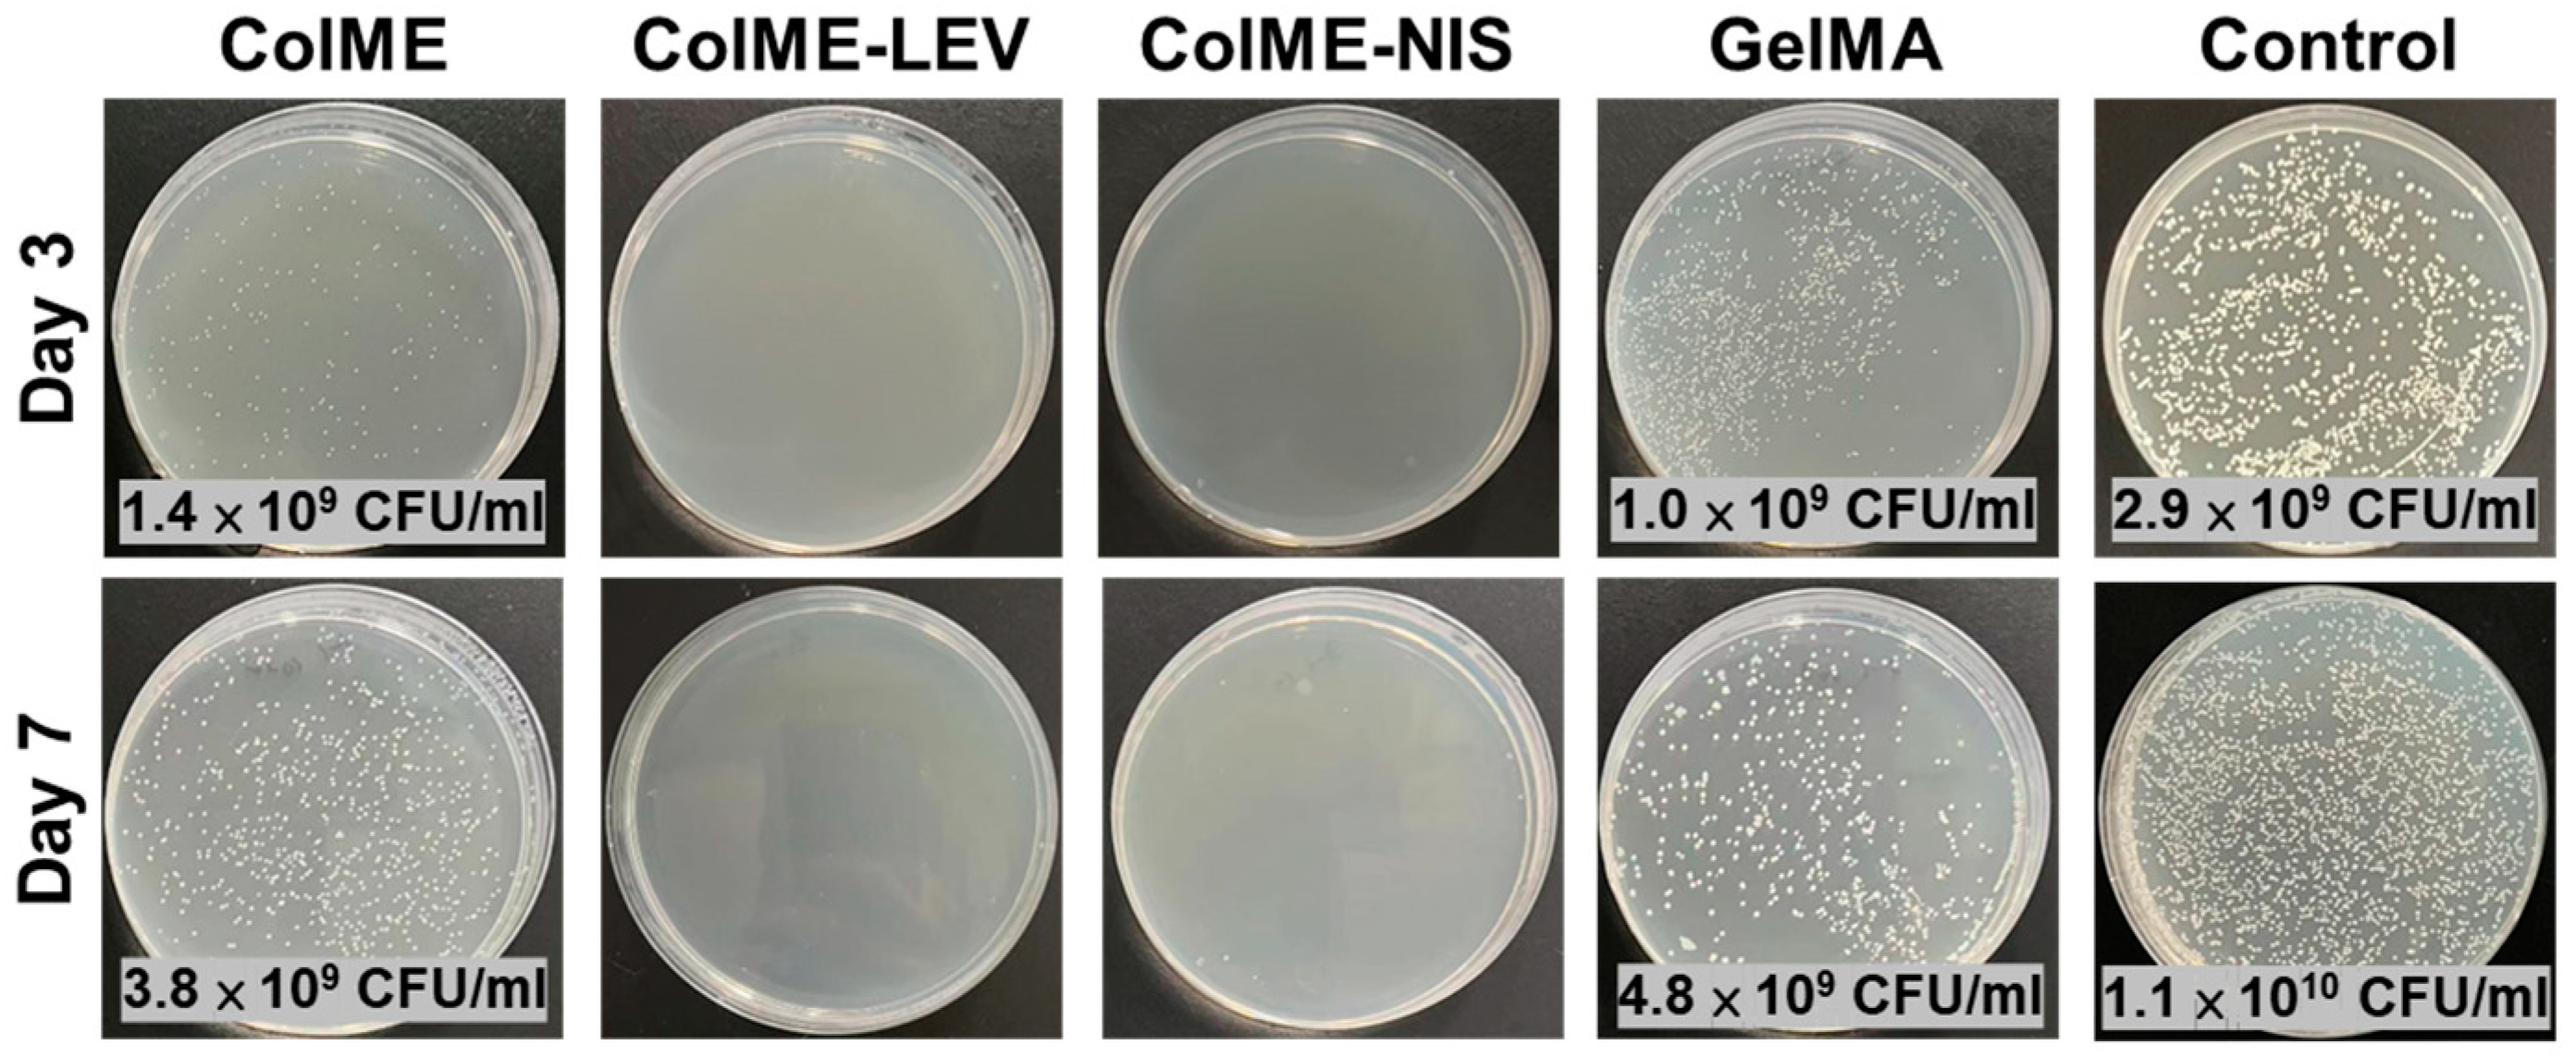
Polymers 15 04701 g006

Development of an In Situ Photo-Crosslinking Antimicrobial Collagen Hydrogel for the Treatment of Infected Wounds
Abstract
:1. Introduction
2. Materials and Methods
2.1. Materials
2.2. Synthesis of Collagen Maleate (ColME) and Gelatin Methacrylate (GelMA)
2.3. Preparation and Characterization of Hydrogels
2.4. In Vitro Studies of the Release of Antibacterial Agents
2.5. In Vitro Studies of Antimicrobial Efficacy
2.6. In Vitro Cytocompatibility
2.7. In Vivo Wound Healing in a Bacterial-Infected Mouse Model
2.8. Statistical Analysis
3. Results and Discussion
3.1. Preparation and Characterization of Hydrogels
3.2. In Vitro Release of Antimicrobial Agents and Their Antimicrobial Efficacy
3.3. In Vitro Cytocompatibility Evaluation
3.4. In Vivo Study on the Healing of Infected Wounds
4. Conclusions
Supplementary Materials
Author Contributions
Funding
Institutional Review Board Statement
Data Availability Statement
Conflicts of Interest
References
- Han, G.; Ceilley, R. Chronic wound healing: A review of current management and treatments. Adv. Ther. 2017, 34, 599–610. [Google Scholar] [CrossRef]
- Serra, R.; Grande, R.; Butrico, L.; Rossi, A.; Settimio, U.F.; Caroleo, B.; Amato, B.; Gallelli, L.; De Franciscis, S. Chronic wound infections: The role of Pseudomonas aeruginosa and Staphylococcus aureus. Expert Rev. Anti-Infect. Ther. 2015, 13, 605–613. [Google Scholar] [CrossRef]
- Bjarnsholt, T.; Kirketerp-Møller, K.; Jensen, P.Ø.; Madsen, K.G.; Phipps, R.; Krogfelt, K.; Høiby, N.; Givskov, M. Why chronic wounds will not heal: A novel hypothesis. Wound Repair Regen. 2008, 16, 2–10. [Google Scholar] [CrossRef]
- Dhivya, S.; Padma, V.V.; Santhini, E. Wound dressings—A review. BioMedicine 2015, 5, 22. [Google Scholar] [CrossRef] [PubMed]
- Boateng, J.; Catanzano, O. Advanced therapeutic dressings for effective wound healing—A review. J. Pharm. Sci. 2015, 104, 3653–3680. [Google Scholar] [CrossRef] [PubMed]
- Brumberg, V.; Astrelina, T.; Malivanova, T.; Samoilov, A. Modern wound dressings: Hydrogel dressings. Biomedicines 2021, 9, 1235. [Google Scholar] [CrossRef]
- Francesko, A.; Petkova, P.; Tzanov, T. Hydrogel dressings for advanced wound management. Curr. Med. Chem. 2018, 25, 5782–5797. [Google Scholar] [CrossRef]
- Jones, A.; Vaughan, D. Hydrogel dressings in the management of a variety of wound types: A review. J. Orthop. Nurs. 2005, 9, S1–S11. [Google Scholar] [CrossRef]
- Chen, X.; Jiang, Z.; Chen, Z.; Wang, D. Application of skin traction for surgical treatment of grade IV pressure sore: A clinical report of 160 cases. Spinal Cord 2011, 49, 76–80. [Google Scholar] [CrossRef]
- Hou, S.; Wang, X.F.; Park, S.; Jin, X.B.; Ma, P.X. Rapid Self-Integrating, Injectable Hydrogel for Tissue Complex Regeneration. Adv. Healthc. Mater. 2015, 4, 1491–1495. [Google Scholar] [CrossRef] [PubMed]
- Lu, M.; Liu, Y.; Huang, Y.C.; Huang, C.J.; Tsai, W.B. Fabrication of photo-crosslinkable glycol chitosan hydrogel as a tissue adhesive. Carbohydr. Polym. 2018, 181, 668–674. [Google Scholar] [CrossRef] [PubMed]
- Kwak, B.S.; Choi, W.; Jeon, J.-w.; Won, J.-I.; Sung, G.Y.; Kim, B.; Sung, J.H. In vitro 3D skin model using gelatin methacrylate hydrogel. J. Ind. Eng. Chem. 2018, 66, 254–261. [Google Scholar] [CrossRef]
- Klotz, B.J.; Gawlitta, D.; Rosenberg, A.J.; Malda, J.; Melchels, F.P. Gelatin-methacryloyl hydrogels: Towards biofabrication-based tissue repair. Trends Biotechnol. 2016, 34, 394–407. [Google Scholar] [CrossRef] [PubMed]
- Velasco-Rodriguez, B.; Diaz-Vidal, T.; Rosales-Rivera, L.C.; García-González, C.A.; Alvarez-Lorenzo, C.; Al-Modlej, A.; Domínguez-Arca, V.; Prieto, G.; Barbosa, S.; Soltero Martínez, J.F.A.; et al. Hybrid methacrylated gelatin and hyaluronic acid hydrogel scaffolds. Preparation and systematic characterization for prospective tissue engineering applications. Int. J. Mol. Sci. 2021, 22, 6758. [Google Scholar] [CrossRef] [PubMed]
- Meng, Z.; Zheng, X.; Tang, K.; Liu, J.; Ma, Z.; Zhao, Q. Dissolution and regeneration of collagen fibers using ionic liquid. Int. J. Biol. Macromol. 2012, 51, 440–448. [Google Scholar] [CrossRef] [PubMed]
- Gaspar-Pintiliescu, A.; Stanciuc, A.-M.; Craciunescu, O. Natural composite dressings based on collagen, gelatin and plant bioactive compounds for wound healing: A review. Int. J. Biol. Macromol. 2019, 138, 854–865. [Google Scholar] [CrossRef] [PubMed]
- Brinkman, W.T.; Nagapudi, K.; Thomas, B.S.; Chaikof, E.L. Photo-Cross-Linking of Type I Collagen Gels in the Presence of Smooth Muscle Cells: Mechanical Properties, Cell Viability, and Function. Biomacromolecules 2003, 4, 890–895. [Google Scholar] [CrossRef]
- Wu, Z.; Liu, J.; Lin, J.; Lu, L.; Tian, J.; Li, L.; Zhou, C. Novel Digital Light Processing Printing Strategy Using a Collagen-Based Bioink with Prospective Cross-Linker Procyanidins. Biomacromolecules 2022, 23, 240–252. [Google Scholar] [CrossRef]
- Maher, M.K.; White, J.F.; Glattauer, V.; Yue, Z.; Hughes, T.C.; Ramshaw, J.A.M.; Wallace, G.G. Variation in Hydrogel Formation and Network Structure for Telo-, Atelo- and Methacrylated Collagens. Polymers 2022, 14, 1775. [Google Scholar] [CrossRef]
- Yang, K.; Sun, J.; Guo, Z.; Yang, J.; Wei, D.; Tan, Y.; Guo, L.; Luo, H.; Fan, H.; Zhang, X. Methacrylamide-modified collagen hydrogel with improved anti-actin-mediated matrix contraction behavior. J. Mater. Chem. B 2018, 6, 7543–7555. [Google Scholar] [CrossRef]
- Pamfil, D.; Nistor, M.T.; Zemljič, L.F.; Vereştiuc, L.; Cazacu, M.; Vasile, C. Preparation and characterization of methyl substituted maleic anhydride: Modified collagens destined for medical applications. Ind. Eng. Chem. Res. 2014, 53, 3865–3879. [Google Scholar] [CrossRef]
- Xu, Z.; Guan, X.; Liu, J.; Fan, H.; Chen, Y. Improving collagen extraction through an alternative strategy based on succinic anhydride pretreatment to retain collagen’s triple-helix structure. J. Appl. Polym. Sci. 2017, 134, 45424. [Google Scholar] [CrossRef]
- Li, C.; Tian, H.; Duan, L.; Tian, Z.; Li, G. Characterization of acylated pepsin-solubilized collagen with better surface activity. Int. J. Biol. Macromol. 2013, 57, 92–98. [Google Scholar] [CrossRef] [PubMed]
- Zhang, Z.; Liu, W.; Li, D.; Li, G. Physicochemical properties of succinylated calfskin pepsin-solubilized collagen. Biosci. Biotechnol. Biochem. 2007, 71, 2057–2060. [Google Scholar] [CrossRef]
- Gunes, O.C.; Ziylan Albayrak, A. Antibacterial Polypeptide nisin containing cotton modified hydrogel composite wound dressings. Polym. Bull. 2021, 78, 6409–6428. [Google Scholar] [CrossRef]
- Pranoto, Y.; Rakshit, S.; Salokhe, V. Enhancing antimicrobial activity of chitosan films by incorporating garlic oil, potassium sorbate and nisin. LWT-Food Sci. Technol. 2005, 38, 859–865. [Google Scholar] [CrossRef]
- Tong, Z.; Ni, L.; Ling, J. Antibacterial peptide nisin: A potential role in the inhibition of oral pathogenic bacteria. Peptides 2014, 60, 32–40. [Google Scholar] [CrossRef]
- Severina, E.; Severin, A.; Tomasz, A. Antibacterial efficacy of nisin against multidrug-resistant Gram-positive pathogens. J. Antimicrob. Chemother. 1998, 41, 341–347. [Google Scholar] [CrossRef]
- Mouritzen, M.V.; Andrea, A.; Qvist, K.; Poulsen, S.S.; Jenssen, H. Immunomodulatory potential of Nisin A with application in wound healing. Wound Repair Regen. 2019, 27, 650–660. [Google Scholar] [CrossRef]
- Pásztor, N.; Rédai, E.; Szabó, Z.-I.; Sipos, E. Preparation and characterization of levofloxacin-loaded nanofibers as potential wound dressings. Acta Marisiensis-Ser. Medica 2017, 63, 66–69. [Google Scholar] [CrossRef]
- Suhail, Z.; Shoukat, H.; Sanbhal, N.; Chowdhry, N.; Bhutto, M.A.; Soomro, S.A.; Ansari, A.Q.; Memon, R.H. Controlled Drug Release and Antibacterial Properties of Levofloxacin-Loaded Silk/Chitosan Green Composite for Wound Dressing. Biomed. Mater. Devices 2022, 1–9. [Google Scholar] [CrossRef]
- Valizadeh, A.; Shirzad, M.; Pourmand, M.R.; Farahmandfar, M.; Sereshti, H.; Amani, A. Levofloxacin nanoemulsion gel has a powerful healing effect on infected wound in streptozotocin-induced diabetic rats. Drug Deliv. Transl. Res. 2021, 11, 292–304. [Google Scholar] [CrossRef] [PubMed]
- Lai, T.; Yu, J.; Tsai, W. Gelatin methacrylate/carboxybetaine methacrylate hydrogels with tunable crosslinking for controlled drug release. J. Mater. Chem. B 2016, 4, 2304–2313. [Google Scholar] [CrossRef] [PubMed]
- ISO 10993-5; Biological Evaluation of Medical Devices—Part 5: Tests for In Vitro Cytotoxicity. ISO: Geneva, Switzerland, 2009.
- Gevariya, H.B.; Gami, S.; Patel, N. Formulation and characterization of levofloxacin-loaded biodegradable nanoparticles. Asian J. Pharm. (AJP) 2011, 5, 114. [Google Scholar] [CrossRef]
- Hu, Y.; Wu, T.; Wu, C.; Fu, S.; Yuan, C.; Chen, S. Formation and optimization of chitosan-nisin microcapsules and its characterization for antibacterial activity. Food Control 2017, 72, 43–52. [Google Scholar] [CrossRef]
- Metcalf, D.G.; Bowler, P.G. Biofilm delays wound healing: A review of the evidence. Burn. Trauma 2013, 1, 2321–3868. [Google Scholar] [CrossRef]
- Van De Vyver, M.; Boodhoo, K.; Frazier, T.; Hamel, K.; Kopcewicz, M.; Levi, B.; Maartens, M.; Machcinska, S.; Nunez, J.; Pagani, C. Histology scoring system for murine cutaneous wounds. Stem Cells Dev. 2021, 30, 1141–1152. [Google Scholar] [CrossRef]

Disclaimer/Publisher’s Note: The statements, opinions and data contained in all publications are solely those of the individual author(s) and contributor(s) and not of MDPI and/or the editor(s). MDPI and/or the editor(s) disclaim responsibility for any injury to people or property resulting from any ideas, methods, instructions or products referred to in the content. |
© 2023 by the authors. Licensee MDPI, Basel, Switzerland. This article is an open access article distributed under the terms and conditions of the Creative Commons Attribution (CC BY) license (https://creativecommons.org/licenses/by/4.0/).
Share and Cite
Wu, S.-Y.; Tsai, W.-B. Development of an In Situ Photo-Crosslinking Antimicrobial Collagen Hydrogel for the Treatment of Infected Wounds. Polymers 2023, 15, 4701. https://doi.org/10.3390/polym15244701
Wu S-Y, Tsai W-B. Development of an In Situ Photo-Crosslinking Antimicrobial Collagen Hydrogel for the Treatment of Infected Wounds. Polymers. 2023; 15(24):4701. https://doi.org/10.3390/polym15244701
Chicago/Turabian StyleWu, Song-Yi, and Wei-Bor Tsai. 2023. "Development of an In Situ Photo-Crosslinking Antimicrobial Collagen Hydrogel for the Treatment of Infected Wounds" Polymers 15, no. 24: 4701. https://doi.org/10.3390/polym15244701
APA StyleWu, S.-Y., & Tsai, W.-B. (2023). Development of an In Situ Photo-Crosslinking Antimicrobial Collagen Hydrogel for the Treatment of Infected Wounds. Polymers, 15(24), 4701. https://doi.org/10.3390/polym15244701

